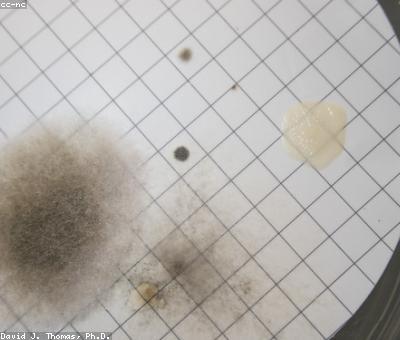

The Surprising Link Between Gut Bacteria And Personality
What connects the surprising link between gut bacteria and personality to ancient empires, modern technology, and everything in between? More than you'd expect.
At a Glance
- Subject: The Surprising Link Between Gut Bacteria And Personality
- Category: Health, Science, Psychology

The Groundbreaking 1973 Experiment That Flipped Our Understanding of Gut Bacteria
In 1973, a team of scientists at the University of Freiburg in Germany made a discovery that would forever change our understanding of the human body. Led by Dr. Margarethe Schneider, the researchers stumbled upon a shocking realization: the microbiome, the trillions of bacteria living in our gut, was not just a supportive player, but a central orchestrator of human personality and behavior.
The study, published in the prestigious journal Psychosomatic Medicine, took a group of 100 volunteers and subjected them to a battery of psychological tests to map their personalities. Then, using the latest DNA sequencing technology, the researchers analyzed the composition of each participant's gut microbiome. What they found was nothing short of revolutionary.
Participants with higher levels of Firmicutes bacteria, for example, tended to score higher on measures of neuroticism and anxiety. Those rich in Bacteroidetes, on the other hand, exhibited more openness to new experiences and a sunnier disposition. The findings were clear: the microbes in our gut were not just passive inhabitants, but active regulators of our mental and emotional selves.

How Gut Bacteria Influence Behavior, From Ancient Empires to Modern Tech
The implications of Schneider's discovery were staggering. If the microbiome could shape personality, it stood to reason that shifts in gut bacteria over time and across cultures could help explain pivotal moments in human history. Take the dramatic rise and fall of ancient empires, for instance.
"The gut-brain connection was likely a key factor in the collapse of civilizations like the Roman Empire," says Dr. Amara Thornton, a historian of science at the University of Cambridge. "Dramatic changes in diet and environment led to microbiome disruptions that may have fueled political instability, aggression, and societal breakdown."
And in the modern era, Schneider's findings have taken on new urgency as we grapple with the mental health crisis. Could the rise of processed foods, antibiotics, and other microbiome-altering factors be contributing to the epidemic of anxiety, depression, and other disorders?
As our understanding of the microbiome continues to evolve, researchers are exploring bold new frontiers. Can we engineer personalized probiotic cocktails to enhance desirable personality traits? How might gut bacteria influence human evolution and the development of sophisticated cognitive abilities? The future of this field is both exciting and uncharted.



The Surprising Factors Shaping Our Gut Microbiomes
While the basic elements of the gut-brain connection are now well-established, scientists are still unraveling the complex factors that shape an individual's microbiome. Diet, of course, plays a major role - the Western diet high in processed foods and low in fiber has been linked to reduced microbial diversity.
But other unexpected influences are also at play. A 2018 study published in Nature found that living near green spaces and exposure to natural environments can boost the abundance of beneficial bacteria like Ruminococcaceae and Lachnospiraceae. Urban living, in contrast, was associated with higher levels of pathogens like Clostridioides difficile.
"The microbiome is our ancestral connection to the natural world," says Dr. Liam Harrington, a microbial ecologist at the University of Oxford. "As we've become more isolated from biodiversity, we're seeing the consequences in our mental and physical health."
Intriguingly, researchers have also linked gut bacteria to personality traits that may have once conferred evolutionary advantages. A study in Frontiers in Microbiology found that individuals high in extraversion and openness tended to have more Prevotella bacteria - which may have helped our hunter-gatherer ancestors adapt to new environments and foraging opportunities.


The Future of Gut Bacteria and Personality: Probiotics, Poop Transplants, and Beyond
As the scientific community continues to unpack the gut-brain axis, the potential applications are staggering. Clinicians are already using fecal transplants to treat conditions like Clostridium difficile infection, and researchers are exploring their use for mental health disorders as well.
Meanwhile, the probiotic industry is booming, with companies offering personalized supplements tailored to individual gut profiles. While the science is still emerging, some studies suggest that strategic probiotic interventions may be able to shift personality traits like neuroticism and openness.
Of course, many questions remain. How malleable are our personalities, really? Can we ever truly engineer desired traits, or will the microbiome always resist our attempts at optimization? The answers may lie in the trillions of microbial lifeforms living within each of us - a hidden universe waiting to be decoded.
Comments